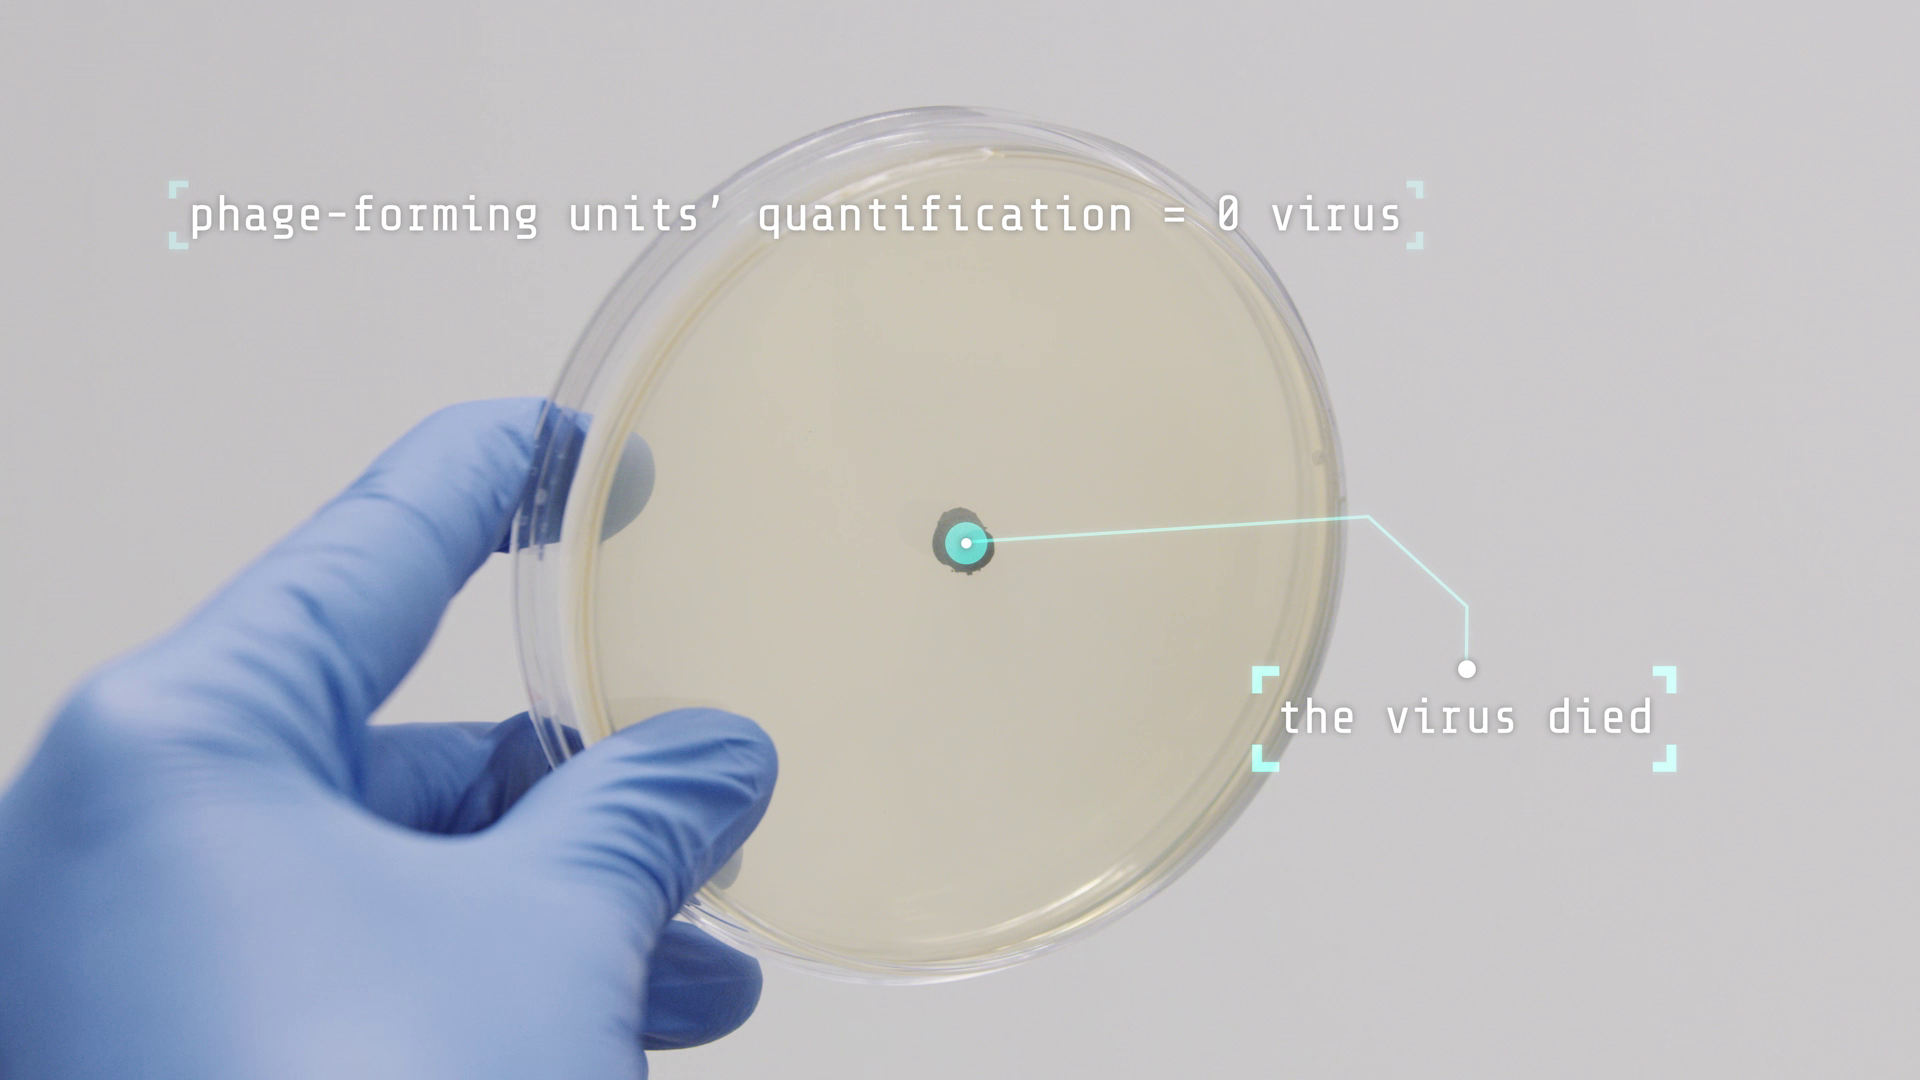

Arcopedico | SM4S
FILME PROMOCIONAL
3′
de Luís Pedro Cardoso
Cimbalino Filmes
A’RCOPEDICO é uma marca de calçado da ROPAR, S.A., com sede em Vila do Conde, Portugal. Nesse video apresenta o projeto SM4S – Safety Materials for Shoes – que tem como objetivo o desenvolvimento de solas para calçado com propriedades antivíricas, de modo a diminuir o risco de contágio e permitir uma maior segurança aos utilizadores.